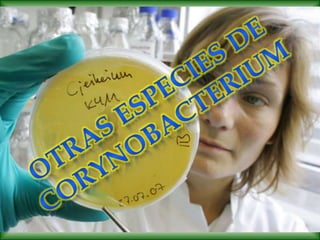
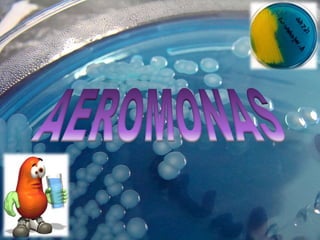

1. El documento describe las características de varias especies de Corinebacterias, incluyendo Corynebacterium diphtheriae, el agente causal de la difteria. 2. La toxina diftérica producida por C. diphtheriae es el principal factor de virulencia y causa daño al inhibir la síntesis de proteínas. 3. El tratamiento incluye antibióticos para eliminar el microorganismo y la administración de antitoxina y vacunación con toxoide diftérico para prevenir futuros casos.